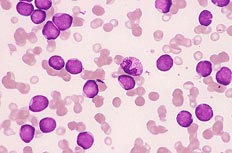
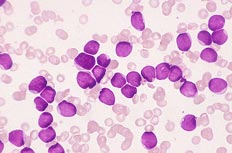
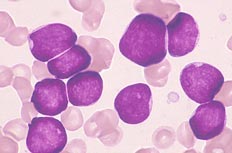

症例29
| 年齢 | 30歳代 | |||
|---|---|---|---|---|
| 現病歴 | 1月中旬風邪症状(発熱38.4℃)から、血液検査にて白血病を診断され入院治療となる. | |||
| 血液学所見 | WBC(/μL) | 90,000 | RBC(万/μL) | 220 |
| Hb(g/dL) | 6.6 | Ht(%) | 20.5 | |
| PLT(万/μL) | 5.1 | MCV(fL) | 93.2 | |
| MCH(pg) | 30 | MCHC(%) | 32.2 | |
| 血液像(%) | Blast様 | 99.0 | ||
| 骨髄所見 | NCC(万/μL) | 15.6 | ||
| Blast様(%) | 100 | |||
| 生化学所見 | LDH 645 U/L | |||
| 表面形質 | CD7(+) | |||
| 染色体所見 | 46,XY | |||
![]() |
![]() |
|
|---|---|---|
| [末梢血×400.MG染色] N/C比の高い芽球様細胞が多くみられる. |
[末梢血×1000.MG染色] 小型でクロマチンの粗荒な芽球様細胞は核形不整がみられる. |
|
![]() |
![]() |
|
| [骨髄×400.MG染色] N/C比の高い芽球様細胞が優位である. |
[骨髄×1000.MG染色] 芽球様細胞の大きさは均一で、PO染色は陰性である. |
|
![]() |
||
| [骨髄×1000.MG染色] 芽球様細胞のクロマチンは粗荒で、PAS染色は陰性である. |
||
正解 : 1 急性骨髄性白血病(系統不詳)
拡大した形態画像には、解説が含まれています。
| 年齢 | 30歳代 |
|---|---|
| 〜前発信〜 | |
| 末梢血所見から | 白血球の著増 (90,000/μL)に伴い芽球様細胞の増加がみられた. 芽球様細胞については、PO染色を行い系統を考える. |
| 骨髄所見から | 骨髄は芽球様細胞で満たされ、それらの形態は末梢血、骨髄ともに N/C比は低く小型のものが優位で、核には若干のうねり状や核小体を有するものがみられた. |
| 細胞化学所見から | 芽球様細胞の系統を推測する意味からまずPO染色を行うが、N/C比が 高いことからPAS染色 (リンパ系を考慮)も並行して行う.本例は共に陰性であった. |
| 【形態診断】 | 形態学的ならびにPO染色が陰性より次を疑った. @急性リンパ性白血病、A急性非リンパ性白血病(PO陰性急性骨髄性白血病) |
| 〜後発信〜 | |
| 表面形質から | 顆粒球・単球マーカー、リンパ系マーカー、血小板マーカーはすべて陰性で、CD7のみが高率 (97%)陽性を呈した. |
| 分子生物学的から | 46,XY |
| 【臨床診断】 | PO陰性の急性白血病の範疇から、確診となるマーカーにて特異的所見は得られず、CD7のみ陽性より未分化型が推測されるものの芽球様細胞の明確な系統帰属は不明であった. 経過も思わしくなく入院後1ヶ月を待たずして死亡される. |
| WHO分類(2017) | 系統不明な急性白血病(acute leukemias of ambiqupus lineage ☆急性未分化性白血病(acute undifferentiated leukemia :AUL) |